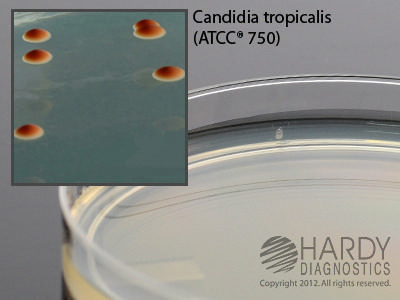

Biggy Agar , Pack Of 10
$ 63.86
|
|
Details:
Medium^ Biggy Agar (Nickersons Agar), For Candida, 15X100Mm Plate, (Nickerson'S Agar; Bismuth Sulfite, Glucose, Glycine, Yeast) For The Selective Isolation And Identification Of Candida Spp.
Additional Information
| SKU | 23815135 |
|---|---|
| UOM | Pack of 10 |
| UNSPSC | 41104307 |
| Manufacturer Part Number | G17 |
| Product Dimensions | 4X4X8 Inches |
| Product Weight | 1 |
